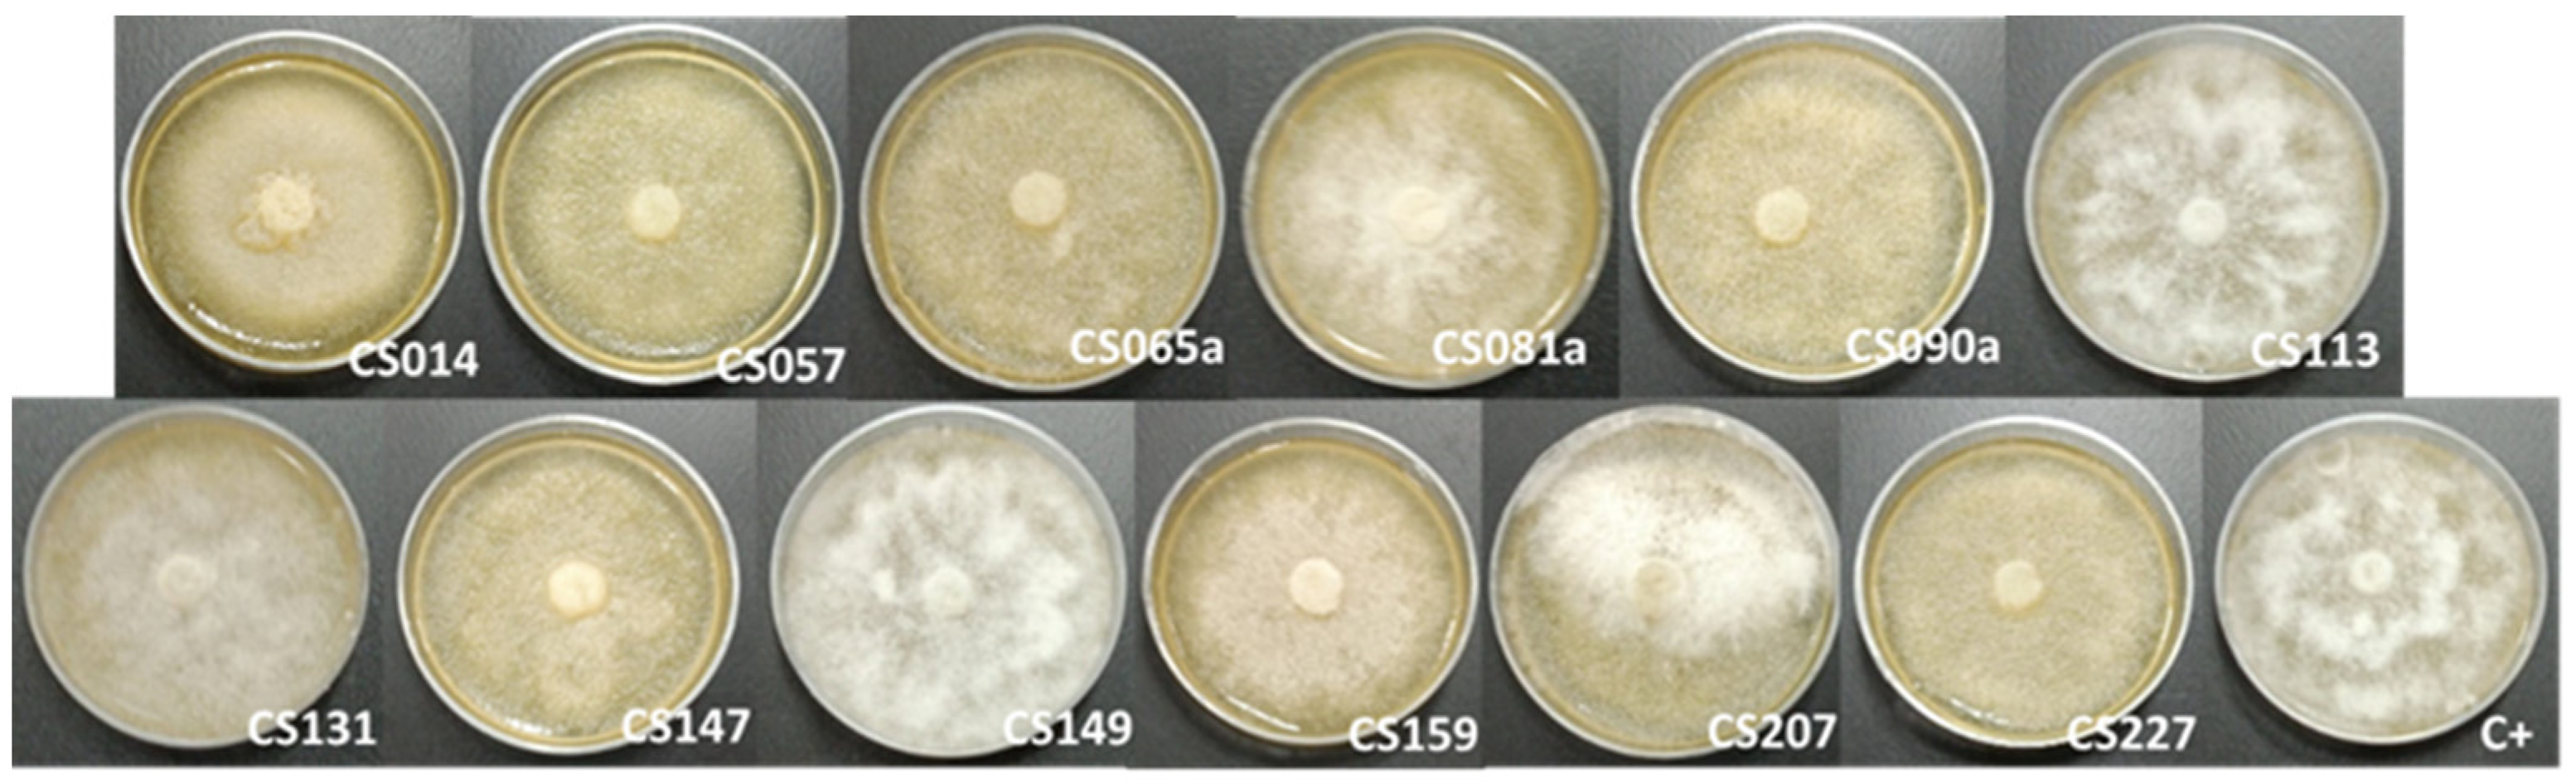
Microorganisms 11 01820 g008

The Volatile Organic Compounds of Streptomyces spp.: An In-Depth Analysis of Their Antifungal Properties
Abstract
1. Introduction
2. Materials and Methods
2.1. Strains and Culture Conditions
2.2. Cocultured Streptomyces spp.–E. weberi
2.3. Dual-Cultured Streptomyces spp.–E. weberi in VOC Chambers
2.4. Capture of VOCs and GC-MS Analysis
2.5. Data Analysis
2.6. Dual Cultures against Other Fungi
2.7. Analysis of Diffusible Compound Production
2.8. Multiple-Cultured Streptomyces spp.–E.weberi
2.9. pH Variation Analysis
3. Results and Discussion
3.1. Cocultured Streptomyces spp.–E. weberi
3.2. Dual-Cultured Streptomyces spp.–E. weberi in VOC Chambers
3.3. Capture of VOCs and GC-MS Analysis
3.3.1. Cocultured E. weberi–Streptomyces sp. CS057
- Camphene: (2,2-dimethyl-3-methylidenebicyclo [2.2.1] heptane). This is a bicyclic terpene produced by various medicinal plants and associated with antibacterial, antifungal, antioxidant, anticancer, antiparasitic, antiviral, anti-inflammatory, and hypolipidemic activities [45]. The remarkable antifungal activity of this compound and its derivatives against diverse pathogenic fungi (Candida albicans, Aspergillus flavus, Microsporum canis, among others) [26,46] supports the hypothesis regarding the activity of this compound, which was exclusively present in the confrontation where antifungal activity was spotted.
- 4-methyl-1-(1-methylethyl)-Bicyclo[3.1.0]hex-2-ene: (beta-thujene). This terpene has not been found to be produced by bacteria. It has been described as a plant metabolite associated with antifungal and antibacterial activity [47,48]. Despite the high percentage of reliability with which this compound has been identified (>90% in each replicate), we cannot assure the identification of this compound since no bibliographical information supports the bacterial production of beta-thujene. It is remarkable that other similar compounds (4-methylene-1-(1-methylethyl)-bicyclo[3.1.0]hexane and 6-hydroxy-5-methyl-6-vinyl-bicyclo[3.2.0]heptan-2-one) were detected in other samples, so we suggest that perhaps they are various modifications of the same compound caused by interactions with other volatiles that may contain this antifungal activity.
- 2-propenyl ester-octanoic acid: Acids of this type are lipid residues from alcoholic fermentation that can be subsequently used as a substrate to produce other compounds. Oxalic acid has been reported to exert antifungal activity at certain levels by membrane disruption [49,50]. Although other fatty acids are present in these samples, octanoic acid is only present in SFM confrontation samples in a large enough quantity to be detected using the method followed, so it can be a degradation product that contributes to the VOC chamber environment conditions that affect fungal growth.
3.3.2. Cocultured E. weberi–Streptomyces sp. CS131
- Linalool oxide: This is a monoterpene acyclic tertiary alcohol that has been described as having antifungal activity against the fungus plant pathogen Guignardia camelliae [65], Candida albicans [66], and Trichophyton rubrum [67]. It has a lot of applications as a vitamin E precursor, in cosmetics, and in detergents, being the most widely used terpene in the food industry because of its fragrant and flavor properties [68]. This compound is also produced by many plants (Coriandrum sativum L., Cymbopogon martini var 11artini, Citrus sinensis Osbeck, among others) as part of their essential oils [69].
- Cis-5-ethenyltetrahydro-alpha, alpha, 5-trimethyl-2-Furanmethanol (linalool oxide B): This is a derivate of the previous molecule, present in the essential oils of several plants of the Pittosporum genus (among others), with cytotoxic, antimicrobial, and anti-inflammatory activities [70].
- 2-Methylenebornane: This is a dehydrated form of 2-methylisoborneol produced by several microorganisms, especially Actinomycetes. This compound, together with geosmin, is responsible for odors in water and soil. It has been reported that several antimicrobial activities are exerted by this compound [65,71].
3.3.3. Cocultured E.weberi–Streptomyces sp. CS147
- 2-methyl-nonadecane: This has been described as being produced by Streptomyces sp. strains, and it is described as a molecule that contributes to the inhibition of phytopathogenic fungi. Streptomyces strain H3-2 has been sought to control Banana Fusarium Wilt because of the production of 2-methylnonadecane, among other volatile compounds [74].
- 1,3-dihydro-5-methoxy-2H-Benzimidazol-2-one: No bioactivity has been described for this compound, but some derivatives of this molecule are related to antimicrobial activities. Agastache honey, which has 1,3-dihydro-5-methyl 2H-benzimidazol-2-one in its composition, has been described as presenting antifungal properties [75].
3.3.4. Cocultured E. weberi–Streptomyces sp. CS014
3.4. Dual Cultures against Other Fungi
3.5. Analysis of Diffusible Compound Production
3.6. Multiple Culture
3.7. pH Variation Analysis
4. Conclusions
Supplementary Materials
Author Contributions
Funding
Data Availability Statement
Acknowledgments
Conflicts of Interest
References
- van der Meij, A.; Worsley, S.F.; Hutchings, M.I.; van Wezel, G.P. Chemical Ecology of Antibiotic Production by Actinomycetes. FEMS Microbiol. Rev. 2017, 41, 392–416. [Google Scholar] [CrossRef]
- Watve, M.G.; Tickoo, R.; Jog, M.M.; Bhole, B.D. How Many Antibiotics Are Produced by the Genus Streptomyces? Arch. Microbiol. 2001, 176, 386–390. [Google Scholar] [CrossRef]
- Hopwood, D.A. Streptomyces in Nature and Medicine: The Antibiotic Makers; Oxford University Press: New York, NY, USA, 2007. [Google Scholar]
- Chater, K.F. Streptomyces Inside-out: A New Perspective on the Bacteria That Provide Us with Antibiotics. Philos. Trans. R. Soc. B Biol. Sci. 2006, 361, 761–768. [Google Scholar] [CrossRef] [PubMed]
- Ceniceros, A.; Cuervo, L.; Méndez, C.; Salas, J.A.; Olano, C.; Malmierca, M.G. A Multidisciplinary Approach to Unraveling the Natural Product Biosynthetic Potential of a Streptomyces Strain Collection Isolated from Leaf-Cutting Ants. Microorganisms 2021, 9, 2225. [Google Scholar] [CrossRef] [PubMed]
- Jones, S.E.; Elliot, M.A. Streptomyces Exploration: Competition, Volatile Communication and New Bacterial Behaviours. Trends Microbiol. 2017, 25, 522–531. [Google Scholar] [CrossRef] [PubMed]
- Effmert, U.; Kalderás, J.; Warnke, R.; Piechulla, B. Volatile Mediated Interactions Between Bacteria and Fungi in the Soil. J. Chem. Ecol. 2012, 38, 665–703. [Google Scholar] [CrossRef]
- Rowan, D.D. Volatile Metabolites. Metabolites 2011, 1, 41–63. [Google Scholar] [CrossRef]
- Piechulla, B.; Lemfack, M.C.; Kai, M. Effects of Discrete Bioactive Microbial Volatiles on Plants and Fungi. Plant Cell Environ. 2017, 40, 2042–2067. [Google Scholar] [CrossRef]
- Cordovez, V.; Carrion, V.J.; Etalo, D.W.; Mumm, R.; Zhu, H.; van Wezel, G.P.; Raaijmakers, J.M. Diversity and Functions of Volatile Organic Compounds Produced by Streptomyces from a Disease-Suppressive Soil. Front. Microbiol. 2015, 6, 1081. [Google Scholar] [CrossRef]
- Schöller, C.E.G.; Gürtler, H.; Pedersen, R.; Molin, S.; Wilkins, K. Volatile Metabolites from Actinomycetes. J. Agric. Food Chem. 2002, 50, 2615–2621. [Google Scholar] [CrossRef]
- Lammers, A.; Lalk, M.; Garbeva, P. Air Ambulance: Antimicrobial Power of Bacterial Volatiles. Antibiotics 2022, 11, 109. [Google Scholar] [CrossRef]
- Li, M.; Bi, Z.; Xie, L.; Sun, G.; Liu, Z.; Kong, Q.; Wei, X.; Chen, C.M. From Starch to Carbon Materials: Insight into the Cross-Linking Reaction and Its Influence on the Carbonization Process. ACS Sustain. Chem. Eng. 2019, 7, 14796–14804. [Google Scholar] [CrossRef]
- Tholl, D.; Hossain, O.; Weinhold, A.; Röse, U.S.R.; Wei, Q. Trends and Applications in Plant Volatile Sampling and Analysis. Plant J. 2021, 106, 314–325. [Google Scholar] [CrossRef] [PubMed]
- Álvarez-García, S.; Mayo-Prieto, S.; Carro-Huerga, G.; Rodríguez-González, Á.; González-López, Ó.; Gutiérrez, S.; Casquero, P.A. Volatile Organic Compound Chamber: A Novel Technology for Microbiological Volatile Interaction Assays. J. Fungi 2021, 7, 248. [Google Scholar] [CrossRef] [PubMed]
- Cuervo, L.; Méndez, C.; Salas, J.A.; Olano, C.; Malmierca, M.G. Volatile Compounds in Actinomycete Communities: A New Tool for Biosynthetic Gene Cluster Activation, Cooperative Growth Promotion, and Drug Discovery. Cells 2022, 11, 3510. [Google Scholar] [CrossRef]
- Klassen, J.L. Microbial Secondary Metabolites and Their Impacts on Insect Symbioses. Curr. Opin. Insect Sci. 2014, 4, 15–22. [Google Scholar] [CrossRef]
- Batey, S.F.D.; Greco, C.; Hutchings, M.I.; Wilkinson, B. Chemical Warfare between Fungus-Growing Ants and Their Pathogens. Curr. Opin. Chem. Biol. 2020, 59, 172–181. [Google Scholar] [CrossRef]
- Malmierca, M.G.; González-Montes, L.; Pérez-Victoria, I.; Sialer, C.; Braña, A.F.; Salcedo, R.G.; Martín, J.; Reyes, F.; Méndez, C.; Olano, C.; et al. Searching for Glycosylated Natural Products in Actinomycetes and Identification of Novel Macrolactams and Angucyclines. Front. Microbiol. 2018, 9, 39. [Google Scholar] [CrossRef]
- Prado-Alonso, L.; Pérez-Victoria, I.; Malmierca, M.G.; Montero, I.; Rioja-Blanco, E.; Martín, J.; Reyes, F.; Méndez, C.; Salas, J.A.; Olano, C. Colibrimycins, Novel Halogenated Hybrid Polyketide Synthase-Nonribosomal Peptide Synthetase (PKS-NRPS) Compounds Produced by Streptomyces Sp. Strain CS147. Appl. Environ. Microbiol. 2022, 88, e0183921. [Google Scholar] [CrossRef]
- Sanchez, L.; Braña, A.F. Cell Density Influences Antibiotic Biosynthesis in Streptomyces Clavuligerus. Microbiology 1996, 142, 1209–1220. [Google Scholar] [CrossRef]
- Fernandez, E.; Weißbach, U.; Sánchez-Reillo, S.; Braña, A.F.; Mendez, C.; Rohr, J.; Salas, J.A. Identification of Two Genes from Streptomyces argillaceus Encoding Glycosyltransferases Involved in Transfer of a Disaccharide during Biosynthesis of the Antitumor Drug Mithramycin. J. Bacteriol. 1998, 180, 4929–4937. [Google Scholar] [CrossRef] [PubMed]
- Hobbs, G.; Frazer, C.M.; Gardner, D.C.J.; Cullum, J.A.; Oliver, S.G. Dispersed Growth of Streptomyces in Liquid Culture. Appl. Microbiol. Biotechnol. 1989, 31, 272–277. [Google Scholar] [CrossRef]
- Alam, K.; Mazumder, A.; Sikdar, S.; Zhao, Y.M.; Hao, J.; Song, C.; Wang, Y.; Sarkar, R.; Islam, S.; Zhang, Y.; et al. Streptomyces: The Biofactory of Secondary Metabolites. Front. Microbiol. 2022, 13, 968053. [Google Scholar] [CrossRef]
- Cuervo, L.; Malmierca, M.G.; García-Salcedo, R.; Méndez, C.; Salas, J.A.; Olano, C.; Ceniceros, A. Co-Expression of Transcriptional Regulators and Housekeeping Genes in Streptomyces Spp.: A Strategy to Optimize Metabolite Production. Microorganisms 2023, 11, 1585. [Google Scholar] [CrossRef]
- Yamaguchi, M.U.; Da Silva, A.P.B.; Ueda-Nakamura, T.; Filho, B.P.D.; Da Silva, C.C.; Nakamura, C.V. Effects of a Thiosemicarbazide Camphene Derivative on Trichophyton mentagrophytes. Molecules 2009, 14, 1796–1807. [Google Scholar] [CrossRef]
- Álvarez-García, S.; Rodríguez-González, Á.; Zanfaño, L.; Gutiérrez, S.; Casquero, P.A. Volatile-Mediated Interactions between Trichoderma harzianum and Acanthoscelides obtectus: A Novel in Vitro Methodology to Evaluate the Impact of Microbial Volatile Compounds on Dry Grain Storage Pests. Biol. Control 2022, 169, 104868. [Google Scholar] [CrossRef]
- Álvarez-García, S.; Manga-Robles, A.; Encina, A.; Gutiérrez, S.; Casquero, P.A. Novel Culture Chamber to Evaluate in Vitro Plant-Microbe Volatile Interactions: Effects of Trichoderma harzianum Volatiles on Wheat Plantlets. Plant Sci. 2022, 320, 111286. [Google Scholar] [CrossRef] [PubMed]
- Rathore, S.; Mukhia, S.; Kumar, R.; Kumar, R. Essential Oil Composition and Antimicrobial Potential of Aromatic Plants Grown in the Mid-Hill Conditions of the Western Himalayas. Sci. Rep. 2023, 13, 4878. [Google Scholar] [CrossRef]
- Anjaneya Reddy, P.L.; Ratnam, V.K.; Lepakshi, B.; Reddy, V.L.; Reddy, N.B. Investigation of chemical and pharmacological properties of essential oils from two Syzygium species of Andhra Pradesh, India. Int. J. Pharm. Pharm. Sci. 2015, 7, 375–380. [Google Scholar]
- Azevedo, M.M.B.; Chaves, F.C.M.; Almeida, C.A.; Bizzo, H.R.; Duarte, R.S.; Campos-Takaki, G.M.; Alviano, C.S.; Alviano, D.S. Antioxidant and Antimicrobial Activities of 7-Hydroxycalamenene-Rich Essential Oils from Croton Cajucara Benth. Molecules 2013, 18, 1128–1137. [Google Scholar] [CrossRef]
- Pedonese, F.; Longo, E.; Torracca, B.; Najar, B.; Fratini, F.; Nuvoloni, R. Antimicrobial and Anti-Biofilm Activity of Manuka Essential Oil against Listeria Monocytogenes and Staphylococcus Aureus of Food Origin. Ital. J. Food Saf. 2022, 11, 10039. [Google Scholar] [CrossRef]
- Fratini, F.; Forzan, M.; Turchi, B.; Mancini, S.; Alcamo, G.; Pedonese, F.; Pistelli, L.; Najar, B.; Mazzei, M. In Vitro Antibacterial Activity of Manuka (Leptospermum scoparium J.R. et G. Forst) and Winter Savory (Satureja montana L.) Essential Oils and Their Blends against Pathogenic E. coli Isolates from Pigs. Animals 2020, 10, 2202. [Google Scholar] [CrossRef]
- Silva-Trujillo, L.; Quintero-Rueda, E.; Stashenko, E.E.; Conde-Ocazionez, S.; Rondón-Villarreal, P.; Ocazionez, R.E. Essential Oils from Colombian Plants: Antiviral Potential against Dengue Virus Based on Chemical Composition, In Vitro and In Silico Analyses. Molecules 2022, 27, 6844. [Google Scholar] [CrossRef] [PubMed]
- Ferreira, O.O.; Cruz, J.N.; de Moraes, Â.A.B.; Franco, C.d.J.P.; Lima, R.R.; Dos Anjos, T.O.; Siqueira, G.M.; Do Nascimento, L.D.; Cascaes, M.M.; de Oliveira, M.S.; et al. Essential Oil of the Plants Growing in the Brazilian Amazon: Chemical Composition, Antioxidants, and Biological Applications. Molecules 2022, 27, 4373. [Google Scholar] [CrossRef] [PubMed]
- Joshi, S.; Mishra, D.; Bisht, G.; Singh Khetwal, K. Essential oil composition and antimicrobial activity of Lobelia pyramidalis Wall. EXCLI J. 2011, 10, 274–279. [Google Scholar] [PubMed]
- Joller, C.; De Vrieze, M.; Moradi, A.; Fournier, C.; Chinchilla, D.; L’Haridon, F.; Bruisson, S.; Weisskopf, L. S-Methyl Methanethiosulfonate: Promising Late Blight Inhibitor or Broad Range Toxin? Pathogens 2020, 9, 496. [Google Scholar] [CrossRef]
- Cao, Y.; Zhang, H.; Liu, H.; Liu, W.; Zhang, R.; Xian, M.; Liu, H. Biosynthesis and Production of Sabinene: Current State and Perspectives. Appl. Microbiol. Biotechnol. 2018, 102, 1535–1544. [Google Scholar] [CrossRef]
- Leunissen, M.; Davidson, V.J.; Kakuda, Y. Analysis of Volatile Flavor Components in Roasted Peanuts Using Supercritical Fluid Extraction and Gas Chromatography-Mass Spectrometry. J. Agric. Food Chem. 1996, 44, 2694–2699. [Google Scholar] [CrossRef]
- Miniyar, P.; Murumkar, P.R.; Patil, P.S.; Barmade, M.A.; Bothara, K.G. Unequivocal role of pyrazine ring in medicinally important compounds: A review. Mini Rev. Med. Chem. 2013, 13, 1607–1625. [Google Scholar] [CrossRef]
- Monreal, C.M.; Schnitzer, M. The Chemistry and Biochemistry of Organic Components in the Soil Solutions of Wheat Rhizospheres. Adv. Agron. 2013, 121, 179–251. [Google Scholar]
- Hui, L.M.; Zhao, G.D.; Zhao, J.J. δ-Cadinene Inhibits the Growth of Ovarian Cancer Cells via Caspase-Dependent Apoptosis and Cell Cycle Arrest. Int. J. Clin. Exp. Pathol. 2015, 8, 6046–6056. [Google Scholar] [PubMed]
- Sharifi-Rad, J.; Hoseini-Alfatemi, S.M.; Sharifi-Rad, M.; Sharifi-Rad, M.; Iriti, M.; Sharifi-Rad, M.; Sharifi-Rad, R.; Raeisi, S. Phytochemical Compositions and Biological Activities of Essential Oil from Xanthium strumarium L. Molecules 2015, 20, 7034–7047. [Google Scholar] [CrossRef]
- Bentley, R.; Meganathan, R. Geosmin and Methylisoborneol Biosynthesis in Streptomycetes. Evidence for an Isoprenoid Pathway and Its Absence in Non-Differentiating Isolates. FEBS Lett. 1981, 125, 220–222. [Google Scholar] [CrossRef] [PubMed]
- Hachlafi, N.E.L.; Aanniz, T.; El Menyiy, N.; El Baaboua, A.; El Omari, N.; Balahbib, A.; Shariati, M.A.; Zengin, G.; Fikri-Benbrahim, K.; Bouyahya, A. In Vitro and in Vivo Biological Investigations of Camphene and Its Mechanism Insights: A Review. Food Rev. Int. 2021, 39, 1799–1826. [Google Scholar] [CrossRef]
- El Silva, K.S.F.; DaS Neto, B.R.; Zambuzzi-Carvalho, P.F.; De Oliveira, C.M.A.; Pires, L.B.; Kato, L.; Bailão, A.M.; Parente-Rocha, J.A.; Hernández, O.; Ochoa, J.G.M.; et al. Response of Paracoccidioides lutzii to the Antifungal Camphene Thiosemicarbazide Determined by Proteomic Analysis. Future Microbiol. 2018, 13, 1473–1496. [Google Scholar] [CrossRef]
- Hong, E.-J.; Na, K.-J.; Choi, I.-G.; Choi, K.-C.; Jeung, E.-B. Antibacterial and Antifungal Effects of Essential Oils from Coniferous Trees. Biol. Pharm. Bull. 2004, 27, 863–866. [Google Scholar] [CrossRef]
- Amiguet, V.T.; Petit, P.; Ta, C.A.; Nuñez, R.; Sánchez-Vindas, P.; Alvarez, L.P.; Smith, M.L.; Arnason, J.T.; Durst, T. Phytochemistry and Antifungal Properties of the Newly Discovered Tree Pleodendron costaricense. J. Nat. Prod. 2006, 69, 1005–1100. [Google Scholar] [CrossRef] [PubMed]
- Guimarães, A.; Venâncio, A. The Potential of Fatty Acids and Their Derivatives as Antifungal Agents: A Review. Toxins 2022, 14, 188. [Google Scholar] [CrossRef]
- Bae, Y.S.; Rhee, M.S. Short-Term Antifungal Treatments of Caprylic Acid with Carvacrol or Thymol Induce Synergistic 6-Log Reduction of Pathogenic Candida albicans by Cell Membrane Disruption and Efflux Pump Inhibition. Cell. Physiol. Biochem. 2019, 53, 285–300. [Google Scholar]
- Cai, J.; Wang, S.; Gao, Y.; Wang, Q. Antibacterial Activity and Mechanism of Polygonum orientale L. Essential Oil against Pectobacterium carotovorum Subsp. Carotovorum. Foods 2022, 11, 1585. [Google Scholar] [CrossRef]
- Prasanna Anjaneya Reddy, L.; Venkata Ratnam, L. Chemical Profile, Antioxidant and Antimicrobial Activity of Essential Oils from Boswellia ovalifoliolata Bal. et. Henry. Int. J. Pharm. Clin. Res. 2015, 7, 96–101. [Google Scholar]
- John Umaru, I.; Umaru, K.I.; Umaru, H.A. Phytochemical Screening, Isolation, Characterization of Bioactive and Biological Activity of Bungkang, (Syzygium polyanthum) Root-Bark Essential Oil. KJFHC 2020, 6, 5–21. [Google Scholar]
- Kong, W.L.; Ni, H.; Wang, W.Y.; Wu, X.Q. Antifungal Effects of Volatile Organic Compounds Produced by Trichoderma koningiopsis T2 against Verticillium Dahliae. Front. Microbiol. 2022, 13, 1013468. [Google Scholar] [CrossRef]
- Blin, K.; Shaw, S.; Kloosterman, A.M.; Charlop-Powers, Z.; Van Wezel, G.P.; Medema, M.H.; Weber, T. AntiSMASH 6.0: Improving Cluster Detection and Comparison Capabilities. Nucleic Acids Res. 2021, 49, W29–W35. [Google Scholar] [CrossRef] [PubMed]
- Martín-Sánchez, L.; Singh, K.S.; Avalos, M.; Van Wezel, G.P.; Dickschat, J.S.; Garbeva, P. Phylogenomic Analyses and Distribution of Terpene Synthases among Streptomyces. Beilstein J. Org. Chem. 2019, 15, 1181–1193. [Google Scholar] [CrossRef] [PubMed]
- Franco, C.R.P.; Alves, P.B.; Andrade, D.M.; de Jesus, H.C.R.; Silva, E.J.S.; Santos, E.A.B.; Antoniolli, Â.R.; Quintans-Júnior, L.J. Essential Oil Composition and Variability in Hyptis fruticosa. Rev. Bras. Farmacogn. 2011, 21, 24–32. [Google Scholar] [CrossRef]
- Fernando, W.G.D.; Ramarathnam, R.; Krishnamoorthy, A.S.; Savchuk, S.C. Identification and Use of Potential Bacterial Organic Antifungal Volatiles in Biocontrol. Soil Biol. Biochem. 2005, 37, 955–964. [Google Scholar] [CrossRef]
- Paulitz, T.; Nowak-Thompson, B.; Gamard, P.; Tsang, E.; Loper, J. A novel antifungal furanone from Pseudomonas aureofaciens, a biocontrol agent of fungal plant pathogens. J. Chem. Ecol. 2000, 26, 1515–1524. [Google Scholar] [CrossRef]
- Bhatia, S.P.; Letizia, C.S.; Api, A.M. Fragrance Material Review on Beta-Caryophyllene Alcohol. Food Chem. Toxicol. 2008, 46, S95–S96. [Google Scholar] [CrossRef]
- Api, A.M.; Belsito, D.; Botelho, D.; Bruze, M.; Burton, G.A.; Buschmann, J.; Dagli, M.L.; Date, M.; Dekant, W.; Deodhar, C.; et al. RIFM Fragrance Ingredient Safety Assessment, β-Caryophyllene Alcohol, CAS Registry Number 472-97-9. FCT 2018, 122, S566–S572. [Google Scholar] [CrossRef]
- Baldissera, M.D.; Souza, C.F.; Grando, T.H.; Doleski, P.H.; Boligon, A.A.; Stefani, L.M.; Monteiro, S.G. Hypolipidemic Effect of β-Caryophyllene to Treat Hyperlipidemic Rats. Naunyn-Schmiedeberg’s Arch. Pharmacol. 2017, 390, 215–223. [Google Scholar] [CrossRef] [PubMed]
- El-Reedy, A.A.M.; Soliman, N.K. Synthesis, Biological Activity and Molecular Modeling Study of Novel 1,2,4-Triazolo[4,3-b][1,2,4,5]Tetrazines and 1,2,4-Triazolo[4,3-b][1,2,4]Triazines. Sci. Rep. 2020, 10, 6137. [Google Scholar] [CrossRef] [PubMed]
- Naik, B.S. Volatile Hydrocarbons from Endophytic Fungi and Their Efficacy in Fuel Production and Disease Control. Egypt. J. Biol. Pest Control 2018, 28, 69. [Google Scholar] [CrossRef]
- Zhang, Z.Z.; Li, Y.B.; Qi, L.; Wan, X.C. Antifungal Activities of Major Tea Leaf Volatile Constituents toward Colletorichum camelliae Massea. J. Agric. Food Chem. 2006, 54, 3936–3940. [Google Scholar] [CrossRef] [PubMed]
- Medeiros, C.; de Sousa, M.; Filho, G.; Freitas, F.; Uchoa, D.; Nobre, M.; Bezerra, A.; Rolim, L.; Morais, A.; Nogueira, T.; et al. Antifungal Activity of Linalool against Fluconazole resistant Clinical Strains of Vulvovaginal Candida albicans and Its Predictive Mechanism of Action. Braz. J. Med. Biol. Res. 2022, 55, e11831. [Google Scholar] [CrossRef]
- de Oliveira Lima, M.I.; Araújo de Medeiros, A.C.; Souza Silva, K.V.; Cardoso, G.N.; de Oliveira Lima, E.; de Oliveira Pereira, F. Investigation of the Antifungal Potential of Linalool against Clinical Isolates of Fluconazole Resistant Trichophyton Rubrum. J. Mycol. Med. 2017, 27, 195–202. [Google Scholar] [CrossRef]
- Derbassi, N.B.; Pedrosa, M.C.; Heleno, S.; Carocho, M.; Ferreira, I.C.F.R.; Barros, L. Plant Volatiles: Using Scented Molecules as Food Additives. Trends Food Sci. Technol. 2022, 122, 97–103. [Google Scholar] [CrossRef]
- Caputi, L.; Aprea, E. Use of Terpenoids as Natural Flavouring Compounds in Food Industry. Recent Pat. Food Nutr. Agric. 2011, 3, 9–16. [Google Scholar] [CrossRef]
- Satoh, M.; Kusumoto, N.; Matsui, N.; Makino, R.; Hashida, K.; Arai, D.; Liduka, Y.; Ashitani, T. Antitermitic and Antifungal Properties of Enantiopure Linalool and Furanoid Linalool Oxide Confirmed in Lindera umbellata Var. Membranacea. JWCT 2022, 42, 37–45. [Google Scholar] [CrossRef]
- Wang, Z.; Wang, C.; Li, F.; Li, Z.; Chen, M.; Wang, Y.; Qiao, X.; Zhang, H. Fumigant Activity of Volatiles from Streptomyces alboflavus TD-1 against Fusarium moniliforme Sheldon. J. Microbiol. 2013, 51, 477–483. [Google Scholar] [CrossRef]
- Guerrero, A.; Guerrero, E.; Cartuche, L.; Cumbicus, N.; Morocho, V. Chemical Profiling of Hedyosmum cumbalense and Hedyosmum spectabile (Chloranthaceae) Essential Oils, and Their Antimicrobial, Antioxidant, and Anticholinesterase Properties. Plants 2023, 12, 39. [Google Scholar] [CrossRef] [PubMed]
- Silva, D.R.; Endo, E.H.; Filho, B.P.D.; Nakamura, C.V.; Svidzinski, T.I.E.; De Souza, A.; Young, M.C.M.; Tânia, U.N.; Cortez, D.A.G. Chemical Composition and Antimicrobial Properties of Piper ovatum Vahl. Molecules 2009, 14, 1171–1182. [Google Scholar] [CrossRef] [PubMed]
- Zou, N.; Zhou, D.; Chen, Y.; Lin, P.; Chen, Y.; Wang, W.; Xie, J.; Wang, M. A Novel Antifungal Actinomycete Streptomyces Sp. Strain H3-2 Effectively Controls Banana Fusarium Wilt. Front. Microbiol. 2021, 12, 706647. [Google Scholar] [CrossRef]
- Krishnanjaneyulu, I.S.; Saravanan, G.; Vamsi, J.; Supriya, P.; Bhavana, J.U.; Sunil Kumar, M.V. Synthesis, Characterization and Antimicrobial Activity of Some Novel Benzimidazole Derivatives. J. Adv. Pharm. Technol. Res. 2014, 5, 21–27. [Google Scholar] [CrossRef]
- Iraji, A.; Yazdanpanah, S.; Alizadeh, F.; Mirzamohammadi, S.; Ghasemi, Y.; Pakshir, K.; Yang, Y.; Zomorodian, K. Screening the Antifungal Activities of Monoterpenes and Their Isomers against Candida Species. J. Appl. Microbiol. 2020, 129, 1541–1551. [Google Scholar] [CrossRef] [PubMed]
- Da Silva, A.C.R.; Lopes, P.M.; de Azevedo, M.B.; Costa, D.C.M.; Alviano, C.S.; Alviano, D.S. Biological Activities of α-Pinene and β-Pinene Enantiomers. Molecules 2012, 17, 6305–6316. [Google Scholar] [CrossRef] [PubMed]
- Cao, M.; Cheng, Q.; Cai, B.; Chen, Y.; Wei, Y.; Qi, D.; Li, Y.; Yan, L.; Li, X.; Long, W.; et al. Antifungal Mechanism of Metabolites from Newly Isolated Streptomyces Sp. Y1-14 against Banana Fusarium Wilt Disease Using Metabolomics. J. Fungi 2022, 8, 1291. [Google Scholar] [CrossRef]
- Malefo, M.S.; Ramadwa, T.E.; Famuyide, I.M.; McGaw, L.J.; Eloff, J.N.; Sonopo, M.S.; Selepe, M.A. Synthesis and Antifungal Activity of Chromones and Benzoxepines from the Leaves of Ptaeroxylon obliquum. J. Nat. Prod. 2020, 83, 2508–2517. [Google Scholar] [CrossRef]
- Kumari, S.; Kumari, S.; Attri, C.; Sharma, R.; Kulshreshtha, S.; Benali, T.; Bouyahya, A.; Gürer, E.S.; Sharifi-Rad, J. GC-MS Analysis, Antioxidant and Antifungal Studies of Different Extracts of Chaetomium globosum Isolated from Urginea indica. BioMed Res. Int. 2022, 24, 1388850. [Google Scholar] [CrossRef]
- Setzer, W.N.; Owolabi, M.S.; Ogundajo, A.; Ndukwe, N.; Dosoky, N.S. Antimicrobial Activities and Chemical Compositions of Daniellia oliveri and Leptoderris micrantha (Fabaceae) Essential Oils from Nigeria. NPC 2020, 15, 1934578X20965462. [Google Scholar]
- Vukovic, N.; Milosevic, T.; Sukdolak, S.; Solujic, S. Antimicrobial Activities of Essential Oil and Methanol Extract of Teucrium montanum. In Proceedings of the Evidence-based Complementary and Alternative Medicine. Evid. Based Complement. Altern. Med. 2007, 4, 17–20. [Google Scholar] [CrossRef] [PubMed]
- Lawson, S.K.; Sharp, L.G.; Powers, C.N.; McFeeters, R.L.; Satyal, P.; Setzer, W.N. Volatile Compositions and Antifungal Activities of Native American Medicinal Plants: Focus on the Asteraceae. Plants 2020, 9, 126. [Google Scholar] [CrossRef] [PubMed]
- Dhodary, B.; Spiteller, D. Ammonia Production by Streptomyces Symbionts of Acromyrmex Leaf-Cutting Ants Strongly Inhibits the Fungal Pathogen Escovopsis. Microorganisms 2021, 9, 1622. [Google Scholar] [CrossRef] [PubMed]
- Quach, N.T.; Nguyen, Q.H.; Vu, T.H.N.; Le, T.T.H.; Ta, T.T.T.; Nguyen, T.D.; Van Doan, T.; Van Nguyen, T.; Dang, T.T.; Nguyen, X.C.; et al. Plant-Derived Bioactive Compounds Produced by Streptomyces variabilis LCP18 Associated with Litsea cubeba (Lour.) Pers as Potential Target to Combat Human Pathogenic Bacteria and Human Cancer Cell Lines. Braz. J. Microbiol. 2021, 52, 1215–1224. [Google Scholar] [CrossRef]
- Martinet, L.; Naômé, A.; Deflandre, B.; Maciejewska, M.; Tellatin, D.; Tenconi, E.; Smargiasso, N.; De Pauw, E.; Van Wezel, G.P.; Rigali, S. A Single Biosynthetic Gene Cluster Is Responsible for the Production of Bagremycin Antibiotics and Ferroverdin Iron Chelators. mBio 2019, 10, e01230-19. [Google Scholar] [CrossRef]
- Hardham, A.R.; Blackman, L.M. Phytophthora cinnamomi. Mol. Plant Pathol. 2018, 19, 260–285. [Google Scholar] [CrossRef]
- O’Sullivan, C.A.; Belt, K.; Thatcher, L.F. Tackling Control of a Cosmopolitan Phytopathogen: Sclerotinia. Front. Plant Sci. 2021, 12, 707509. [Google Scholar] [CrossRef]
- Aylward, F.O.; Burnum-Johnson, K.E.; Tringe, S.G.; Teiling, C.; Tremmel, D.M.; Moeller, J.A.; Scott, J.J.; Barry, K.W.; Piehowski, P.D.; Nicor, C.D.; et al. Leucoagaricus gongylophorus Produces Diverse Enzymes for the Degradation of Recalcitrant Plant Polymers in Leaf-Cutter Ant Fungus Gardens. Appl. Environ. Microbiol. 2013, 79, 3770–3778. [Google Scholar] [CrossRef]
- Schulz, S.; Dickschat, J.S. Bacterial Volatiles: The Smell of Small Organisms. Nat. Prod. Rep. 2007, 24, 814–842. [Google Scholar] [CrossRef]
- Popowska-Nowak, E.; Bajan, C.; Augustyniuk-Kram, A.; Kolomiec, E.; Chikileva, A.; Lobanok, A. Interactions between Soil Microorganisms: Bacteria, Actinomycetes and Entomopathogenic Fungi of the Genera Beauveria and Paecilomyces. Pol. J. Ecol. 2003, 51, 85–90. [Google Scholar]
- Epsky, N.D.; Heath, R.R.; Dueben, B.D.; Lauzon, C.R.; Proveaux, A.T.; Maccollom, G.B. Attraction of 3-methyl-l-butanol and ammonia identified from Enterobacter agglomerans to Anastrepha suspensa. J. Chem. Ecol. 1998, 24, 1867–1880. [Google Scholar] [CrossRef]

Disclaimer/Publisher’s Note: The statements, opinions and data contained in all publications are solely those of the individual author(s) and contributor(s) and not of MDPI and/or the editor(s). MDPI and/or the editor(s) disclaim responsibility for any injury to people or property resulting from any ideas, methods, instructions or products referred to in the content. |
© 2023 by the authors. Licensee MDPI, Basel, Switzerland. This article is an open access article distributed under the terms and conditions of the Creative Commons Attribution (CC BY) license (https://creativecommons.org/licenses/by/4.0/).
Share and Cite
Cuervo, L.; Álvarez-García, S.; Salas, J.A.; Méndez, C.; Olano, C.; Malmierca, M.G. The Volatile Organic Compounds of Streptomyces spp.: An In-Depth Analysis of Their Antifungal Properties. Microorganisms 2023, 11, 1820. https://doi.org/10.3390/microorganisms11071820
Cuervo L, Álvarez-García S, Salas JA, Méndez C, Olano C, Malmierca MG. The Volatile Organic Compounds of Streptomyces spp.: An In-Depth Analysis of Their Antifungal Properties. Microorganisms. 2023; 11(7):1820. https://doi.org/10.3390/microorganisms11071820
Chicago/Turabian StyleCuervo, Lorena, Samuel Álvarez-García, José A. Salas, Carmen Méndez, Carlos Olano, and Mónica G. Malmierca. 2023. "The Volatile Organic Compounds of Streptomyces spp.: An In-Depth Analysis of Their Antifungal Properties" Microorganisms 11, no. 7: 1820. https://doi.org/10.3390/microorganisms11071820
APA StyleCuervo, L., Álvarez-García, S., Salas, J. A., Méndez, C., Olano, C., & Malmierca, M. G. (2023). The Volatile Organic Compounds of Streptomyces spp.: An In-Depth Analysis of Their Antifungal Properties. Microorganisms, 11(7), 1820. https://doi.org/10.3390/microorganisms11071820

